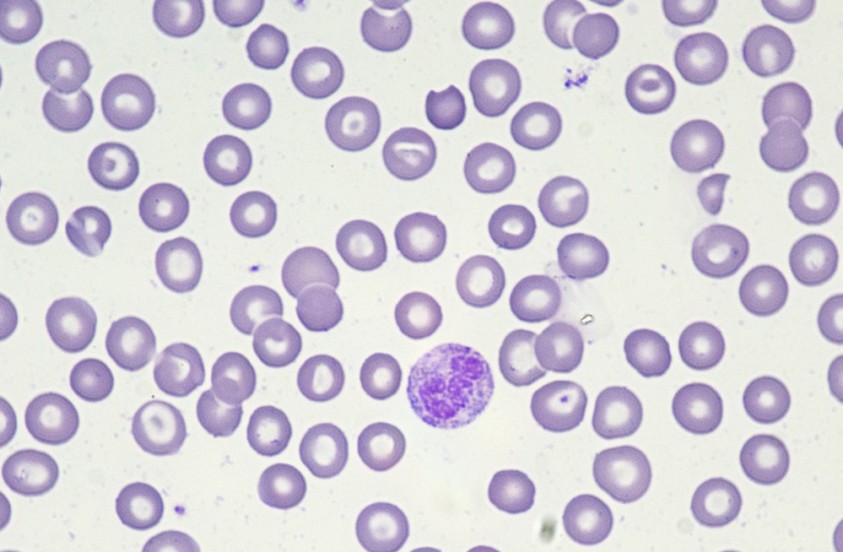
6088_9hvh_3974.jpg

作用机制与影响人体的生理过程
全球唯一采用40kD双链Y型PEG(聚乙二醇)修饰的长效rhG-CSF,通过创新结构设计,分子量更大,更大程度保留生物活性,结构质量更稳定。其主要作用机制是通过刺激骨髓中的造血干细胞,促进中性粒细胞的生成和释放,从而增加外周血中的中性粒细胞数量。中性粒细胞是人体免疫系统的重要组成部分,能够吞噬和杀灭细菌等病原体,防止感染的发生。
适应症与疗效
主要用于非髓性恶性肿瘤患者在接受容易引起发热性中性粒细胞减少症的骨髓抑制性抗癌药物治疗时,降低以发热性中性粒细胞减少症为表现的感染发生率。临床试验表明,能够显著降低放化疗引起的中性粒细胞减少症的发生率,减轻患者的经济负担,同时降低给药剂量,提高疗效和安全性,减少骨髓过度刺激的风险。
使用禁忌与慎用情况
使用存在一些禁忌和慎用情况。对聚乙二醇修饰人粒细胞刺激因子、人粒细胞刺激因子以及对大肠埃希菌表达的其他制剂过敏者禁用。严重肝、肾、心、肺功能障碍者也应慎用。此外,在使用细胞毒性化疗药物前14天到化疗后24小时内,应避免使用。
副作用与监测处理
在使用过程中可能出现一些副作用,包括严重过敏反应、白细胞增多症、脾破裂、急性呼吸窘迫综合征等。对于出现的副作用,应立即停止使用,并进行对症治疗。同时,应密切监测患者的血常规,特别是中性粒细胞计数的变化情况,以及可能出现的过敏反应等症状。
在不同患者群体中的使用注意事项
对于不同年龄段、性别和身体状况的患者,的使用存在一些特殊注意事项。老年患者(年龄≥65岁)与年轻患者(年龄<65岁)在安全性或有效性上未观察到总体差异,但受临床研究受试者例数限制,不排除在临床使用过程中出现差别。儿童患者中的安全性和有效性尚未确定。孕妇和哺乳期妇女应权衡利弊后使用。
与其他药物的相互作用
目前尚未进行和其他药物之间相互作用的研究。但已有研究表明,金属锂可能对嗜中性白细胞的释放有一定的促进作用,接受锂和治疗的患者需要更为频繁地监测中性粒细胞的数量。
使用剂量与疗程
使用剂量和疗程应根据患者的具体情况进行调整。推荐在每个化疗周期抗肿瘤药物给药结束后48小时(±12小时)进行单次皮下注射。对于体重≥45kg的患者,推荐首选按固定剂量2mg进行皮下注射;对于体重<45kg的患者,按体重给药,推荐剂量为33μg/kg。
评估的治疗效果与定期检查
评估的治疗效果主要通过监测患者的中性粒细胞计数和感染发生率等指标。同时,应定期进行血常规检查,以及可能的肺部、肾脏等器官的功能检查,以及时发现并处理可能出现的副作用。
长期使用安全性与耐药性
长期使用安全性尚需进一步观察和研究。目前尚未有关于产生耐药性的报道,但长期使用任何药物都可能存在潜在风险,因此应密切监测患者的病情变化。
特殊人群使用的限制与建议
对于孕妇、哺乳期妇女、儿童和老年人等特殊人群,的使用存在一些限制和建议。孕妇和哺乳期妇女应权衡利弊后使用;儿童患者中的安全性和有效性尚未确定,应谨慎使用;老年患者应根据具体情况调整剂量和疗程。
使用期间的生活方式与饮食调整
在使用期间,患者应保持良好的生活方式和饮食习惯。避免过度劳累和感染,保持充足的睡眠和营养摄入,有助于提高身体的免疫力和抵抗力。
存储与使用方法
应于2~8℃避光保存和运输,避免冷冻或剧烈震荡。使用前应仔细检查药液是否澄清透明,如发现有颗粒物、浑浊或变色,请勿使用。
提高患者依从性的方法
向患者详细解释的作用、副作用和使用注意事项,有助于提高患者的依从性。医生应耐心解答患者的疑问,告知其用药的重要性和必要性,以及可能出现的副作用和应对措施。同时,鼓励患者积极参与治疗过程,定期进行检查和监测,以便及时调整治疗方案。
研发背景与临床研究进展
国家科技重大专项认证的治疗用生物制品1类创新药。其临床研究结果表明,能够显著降低放化疗引起的中性粒细胞减少症的发生率,提高患者的生命质量。未来,特宝生物将继续致力于创新药物的研发,为患者提供更优质的产品与服务。
疑难病例或特殊情况下的综合考虑
对于一些疑难病例或特殊情况,如患者存在严重的肝肾功能障碍、过敏反应史等,应综合考虑使用以及其他治疗方法。医生应根据患者的具体情况制定个性化的治疗方案,确保治疗的安全性和有效性。
综上所述,作为一种新一代长效人粒细胞刺激因子,在肿瘤治疗中发挥着重要作用。通过了解其作用机制、适应症、禁忌和慎用情况、副作用与监测处理等方面的知识,我们可以更好地指导患者合理使用,提高治疗效果和患者的生命质量。